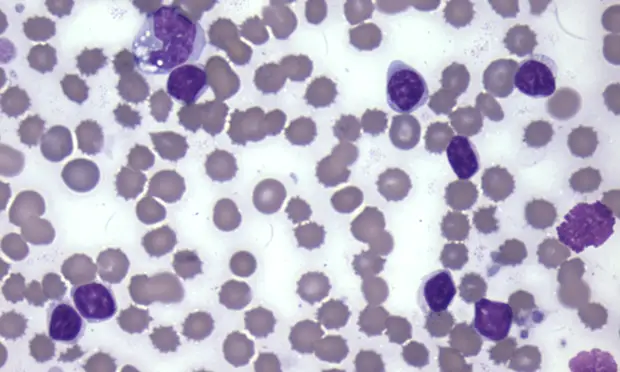
Leukogram-patterns

نتایج حاصل از تست CBC به عنوان بخشی از اطلاعات پایه ای تشخیص مورد استفاده قرار می گیرد. در صورتیکه برای تست CBC از دستگاه های هماتولوژی آنالایزر داخل کلینیک استفاده می شود، برای تأیید نتایج گزارش شده بهتر است ارزیابی اسمیر خونی نیز صورت گیرد و موارد قابل بررسی عبارتند از دیف گلبول های سفید، بررسی سلول های غیر معمول مانند Mast cell، Blasts و گلبول های قرمز هسته دار.
بعد از تأیید نتایج اتوماتیک، ارزیابی لکوگرام که شامل موارد زیر می باشد، برای تشخیص الگوهای لکوگرام باید انجام شود. این موارد عبارتند از:
- شمارش کلی گلبول های سفید (Total WBC Count)
- تعداد مطلق لکوسیت ها
- مورفولوژی لکوسیت ها
در زمان ارزیابی WBC Differentials، تعداد مطلق سلول ها که از فرمول زیر بدست می آید در کنار درصد لکوسیت ها باید مورد بررسی قرار گیرد
- WBC count X Leukocyte percentage